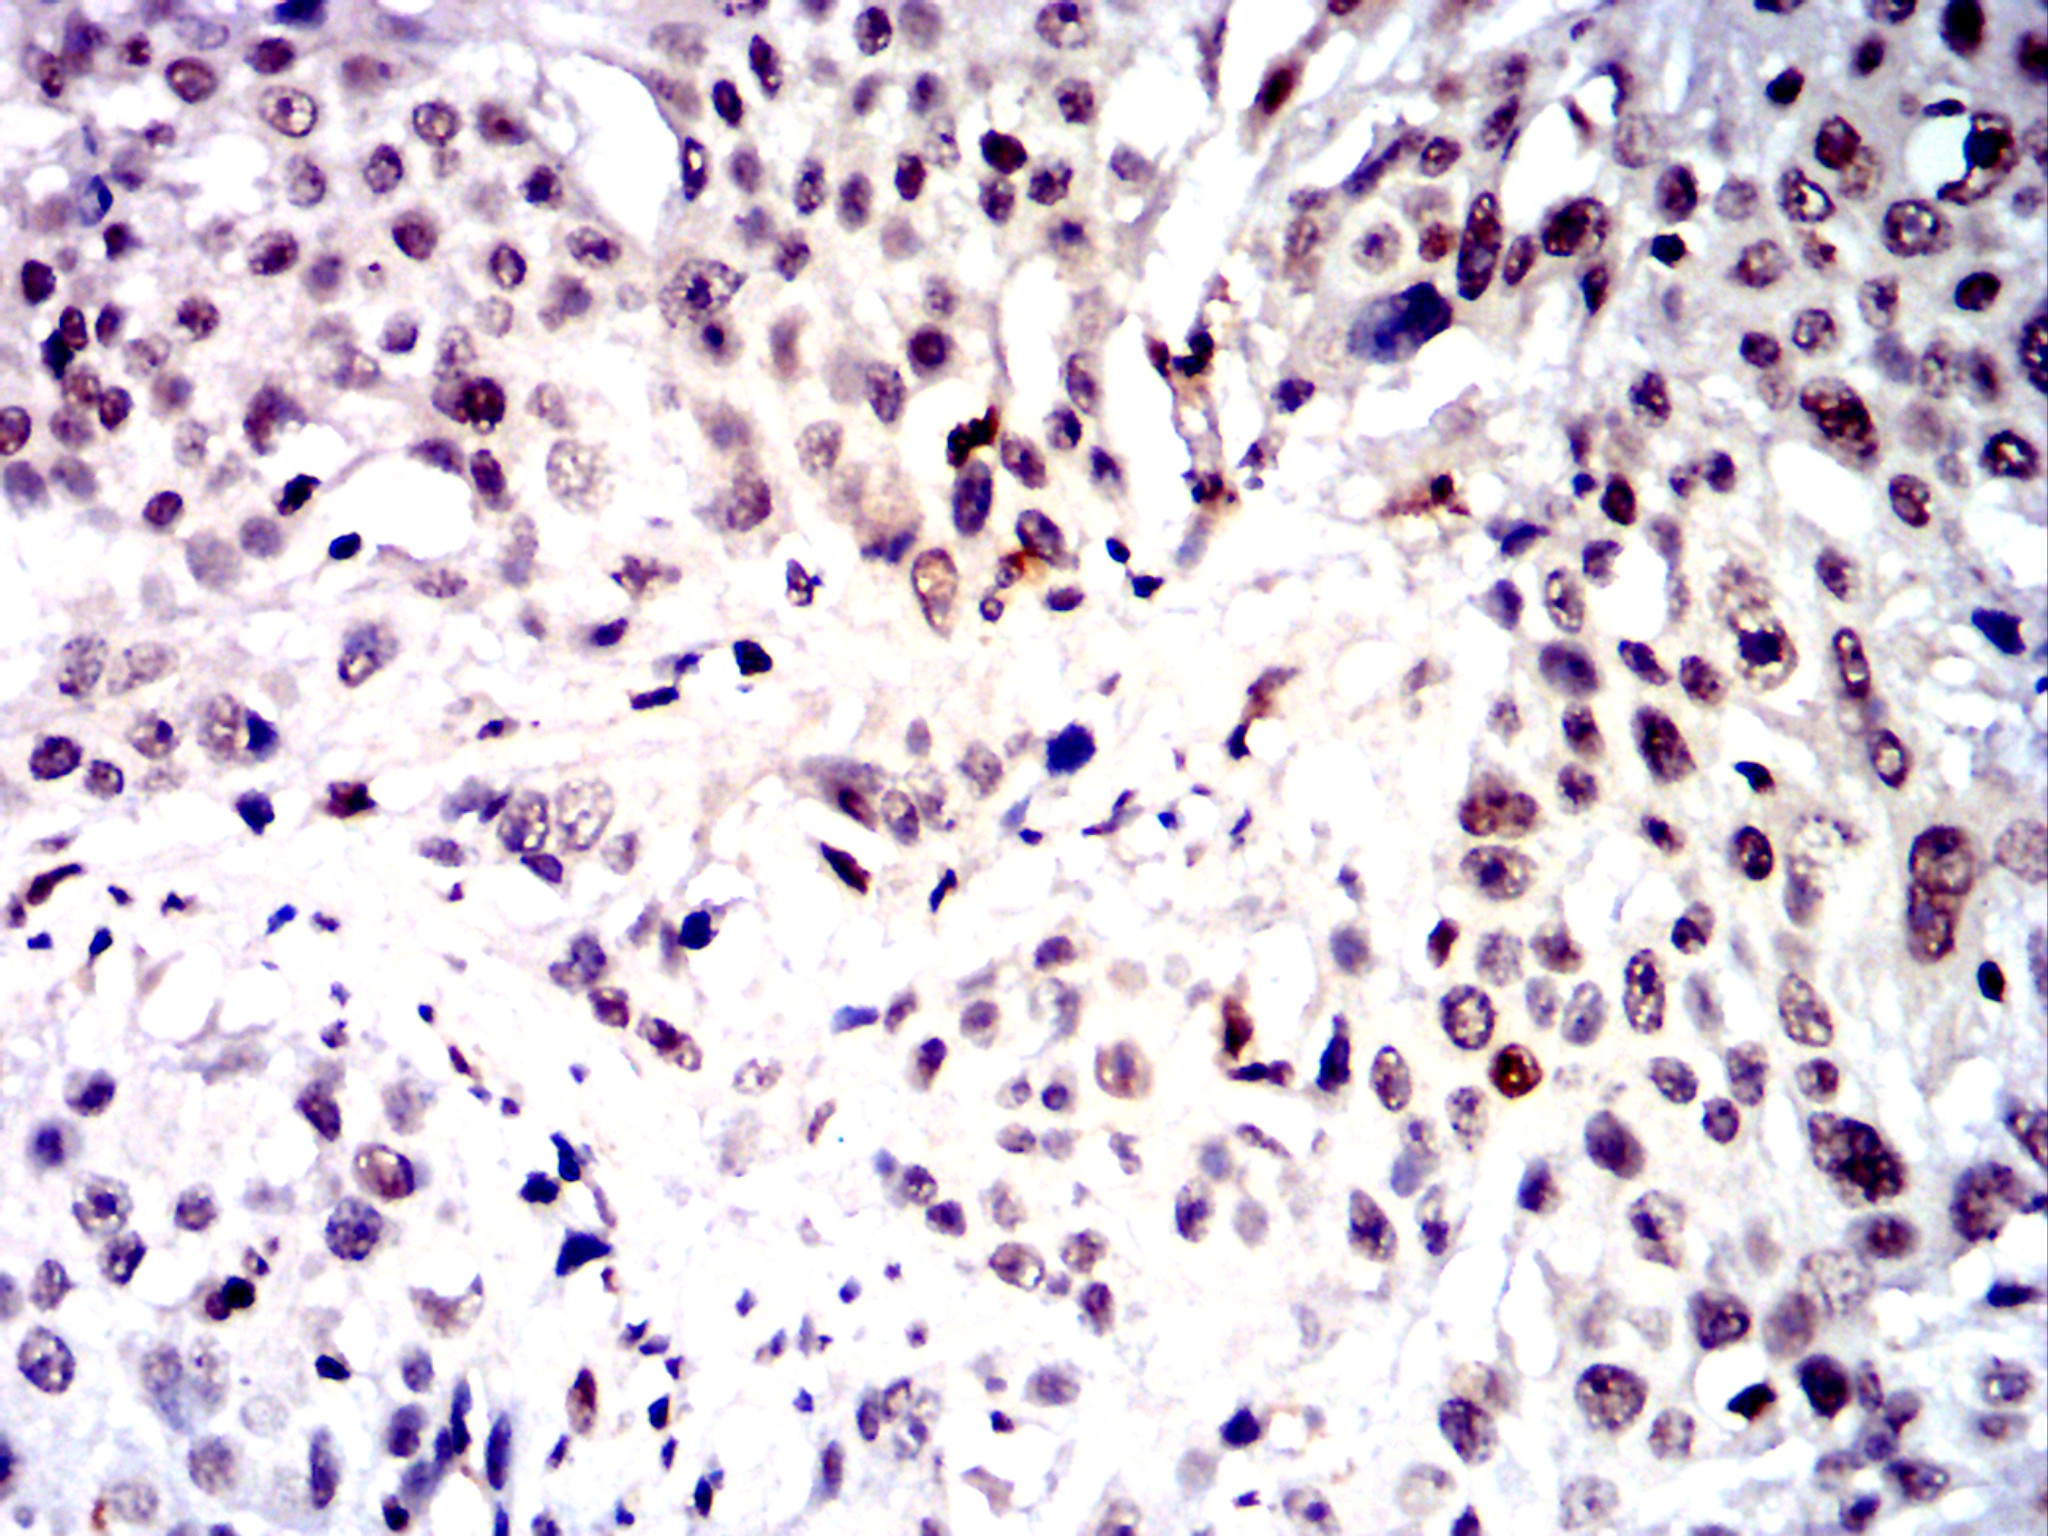
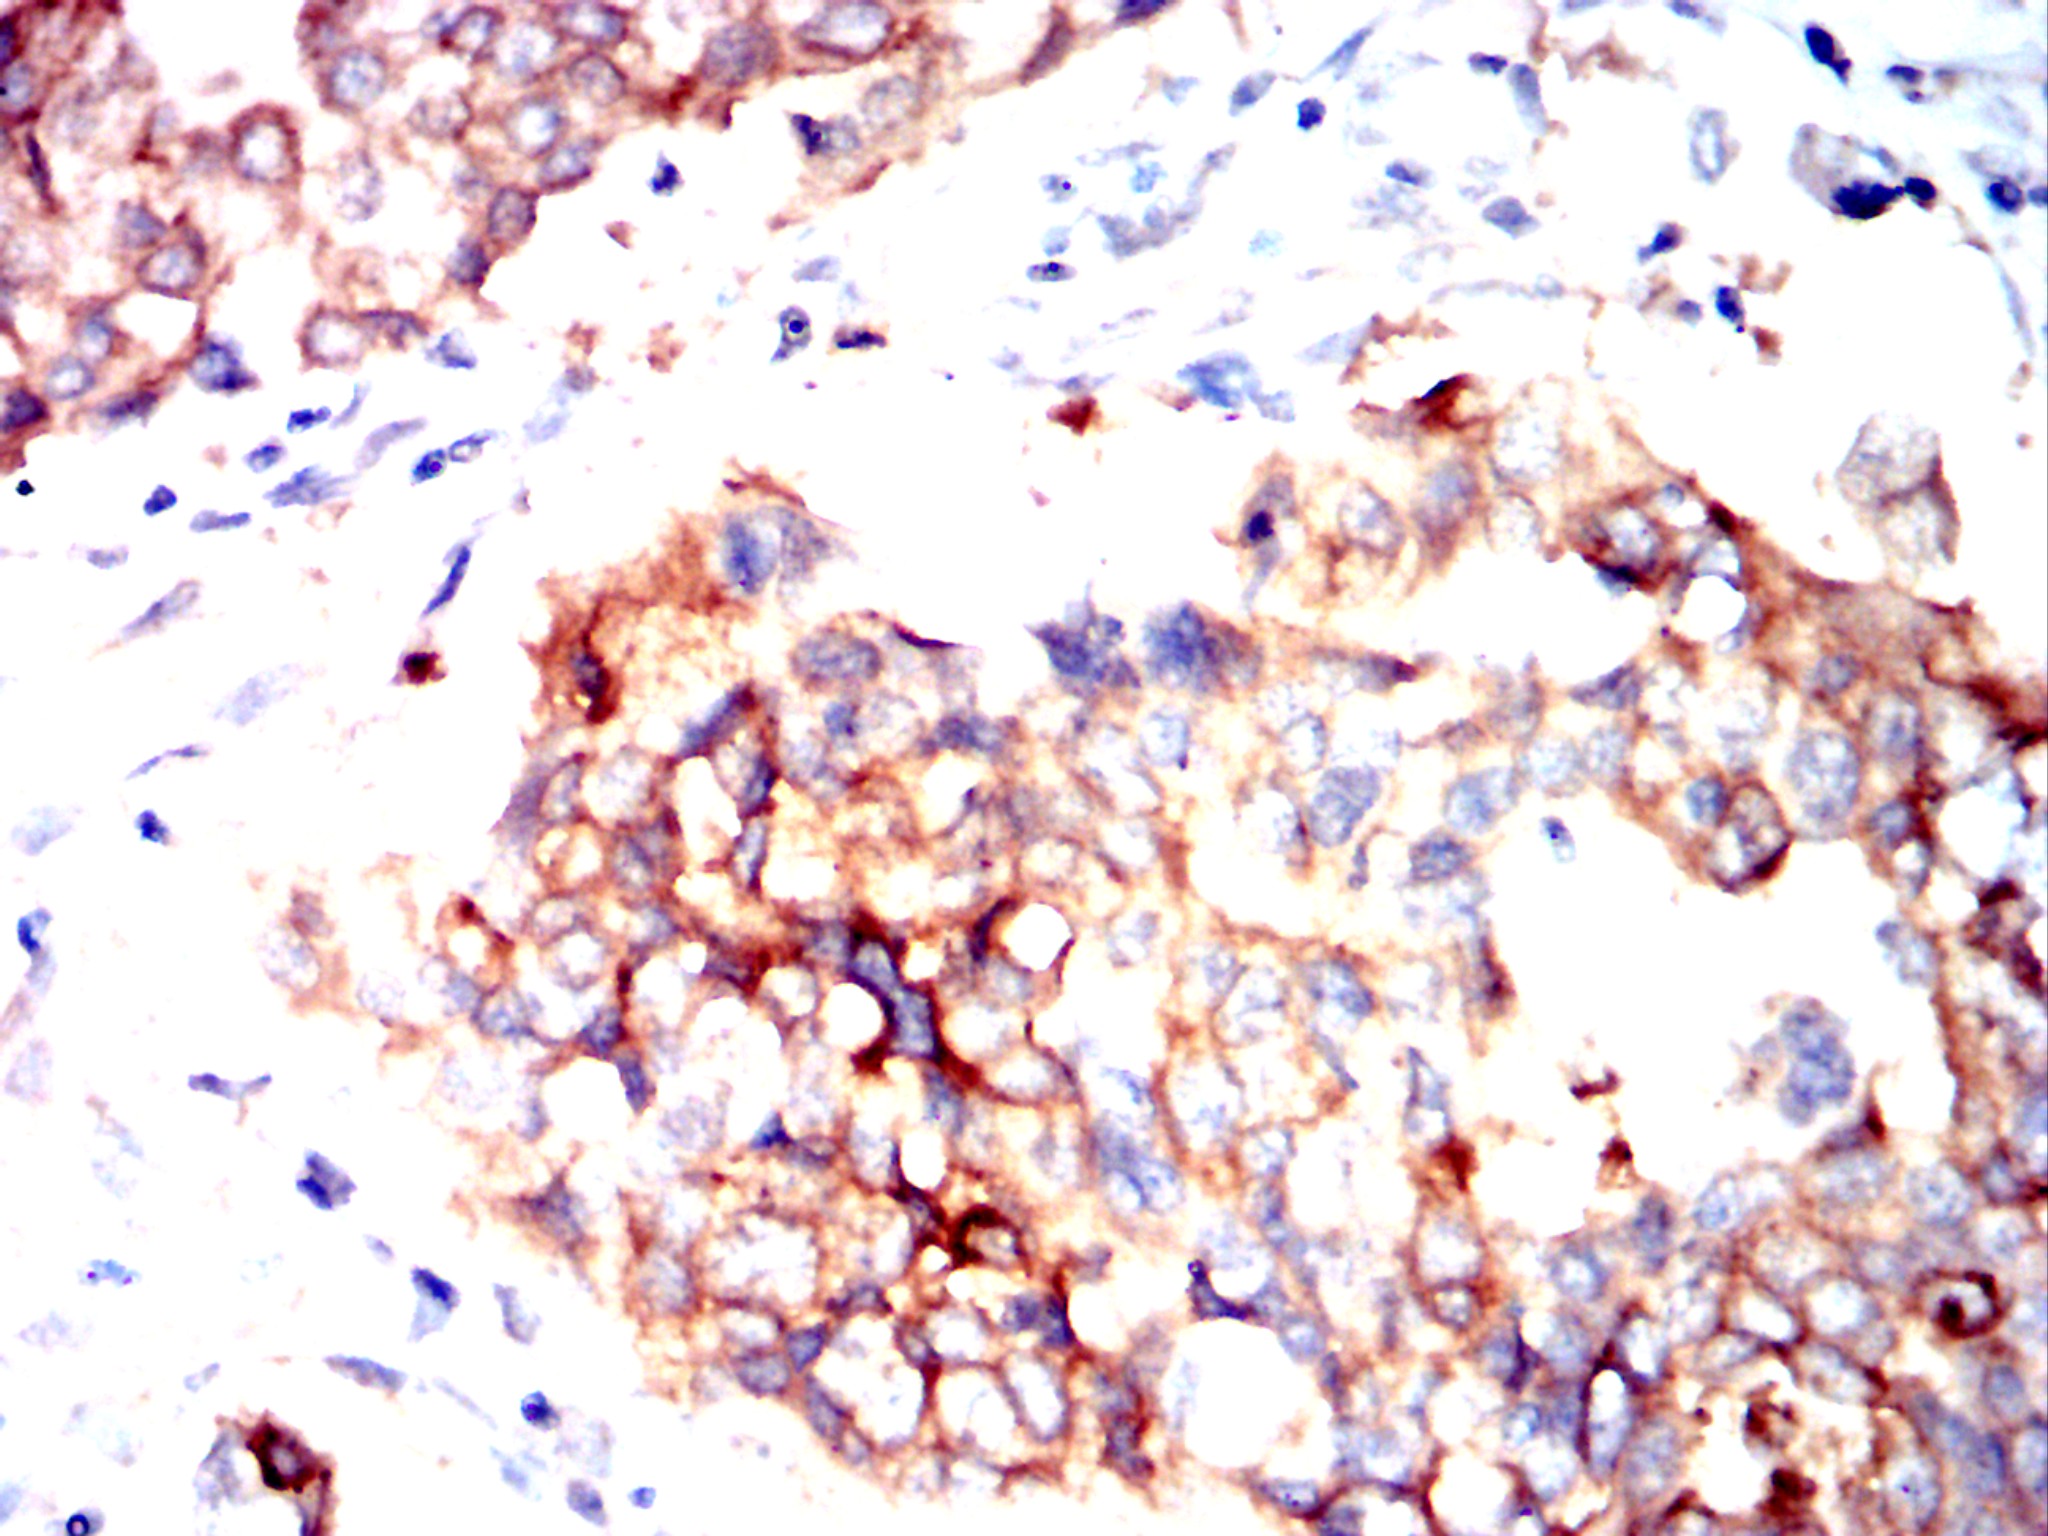

-
分类: 科研抗体货号: 32445别名: CDF;HGF;HSF;BSF2;IL-6;BSF-2;IFNB2;IFN-beta-2应用: IHC,FCM反应种属: Human,Mouse,Rat,Rabbit
-
分类: 科研抗体货号: 32436别名: DRCC1; MUC-13应用: WB,IHC,FCM反应种属: Human, Mouse, Rat
-
分类: 科研抗体货号: 32450别名: C9;DD1;DDH;DDH1;H-37;HBAB;MBAB;HAKRC;DD1/DD2;2-ALPHA-HSD;20-ALPHA-HSD应用: WB,IHC,FCM反应种属: Human,Rabbit
-
分类: 科研抗体货号: 32444别名: BIS;BRM;SNF2;SWI2;hBRM;NCBRS;Sth1p;BAF190;SNF2L2;SNF2LA;hSNF2a应用: WB,IHC反应种属: Human
-
分类: 科研抗体货号: 32435别名: DPB1; HLA-DP; HLA-DPB; HLA-DP1B应用: IHC,FCM反应种属: Human, Rat
-
分类: 科研抗体货号: 32449别名: C14orf78应用: IHC,FCM反应种属: Human,Mouse,Rat,Rabbit
-
分类: 科研抗体货号: 32443别名: 6 His tag; HHHHHH tag应用: WB,IP,IHC,IF,FCM反应种属: Tag
-
分类: 科研抗体货号: 32472别名: HA;HA tag;HA-tag应用: WB,IP,IF,FCM反应种属: Tag
-
分类: 科研抗体货号: 32448别名: Tp44应用: IF,FCM反应种属: Human,Mouse
-
分类: 科研抗体货号: 32458别名: PI3K; p110-alpha应用: IHC,IF,FCM反应种属: Human,Mouse,Rat,Rabbit

鄂公网安备42018502007531号
鄂公网安备42018502007531号

